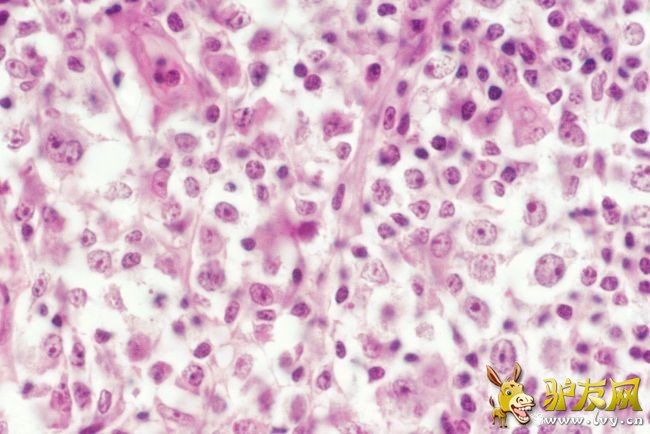
�ǻ�����ܰ���

十大致命類型的癌癥 都是很難治愈的癌癥
癌癥是一種疾病,我們身體的正常細胞生長和分裂,最終死亡,但不正常的癌細胞會無法控制地生長,并且會形成腫塊。但并非所有的腫瘤都被認為是癌癥,有的腫瘤存在于一個不擴散的地方,而且是良性的,增長有限,而有的會不斷侵犯并破壞健康組織,以下是十大致命類型的癌癥。 10.神經(jīng)系統(tǒng)和腦癌
這種癌癥有各種各樣的癥狀,如行為改變、癲癇、嗜睡等。它是最致命的癌癥之一,這種癌癥可以在任何年齡發(fā)生,但在兩種年齡組中最常見,兒童3至12歲,成人40至70歲。 9.胰腺癌
胰腺癌的死亡率很高,而且很難治療。它們之所以很難治療,是因為定位是一個大問題,胰腺位于我們的腹部深處,如果有腫塊很難感覺到,所以即使你有,你也不能很容易地識別出哪里出問題。 8.肝細胞性肝癌
肝細胞癌是一種肝癌,也被認為是惡性肝癌。它是一種慢性肝病,很難治療,如果發(fā)現(xiàn)得早,就有可能通過移植或手術(shù)治療,但在晚期則無法治愈。 7.非霍奇金淋巴瘤
非霍奇金淋巴瘤是各種發(fā)生在淋巴結(jié)和淋巴組織的血癌的全部表達,非霍奇金淋巴瘤有30多種亞型,非霍奇金淋巴瘤比霍奇金淋巴瘤更致命,也更難治愈。 6.結(jié)腸直腸癌
結(jié)腸直腸癌在女性中最常見,結(jié)腸直腸癌的癥狀取決于腫瘤的位置和大小。最常見的癥狀是排便習慣的改變,這可能改變糞便的稠度,并可能在糞便中出現(xiàn)血液,這是一種可怕的癌癥,而且難以治愈。 5.急性淋巴細胞白血病
急性淋巴細胞白血病是一種急性癌癥,在美國每年有超過1400人因此死亡。急性淋巴細胞白血病多見于兒童和老年人,癥狀包括胸痛、嘔吐、咳嗽、呼吸短促、多因血小板減少、頭痛、疲勞等而出血。 4.前列腺癌
與亞洲人、白人或西班牙人相比,前列腺癌在非洲裔美國人中很常見。男性在50歲后很可能被診斷出患有前列腺癌,食用高脂肪的乳制品,肉類,少吃水果和蔬菜,患前列腺癌的風險很高。 3.肝內(nèi)膽管細胞癌
這是一種罕見但危險的癌癥發(fā)生在攜帶膽汁的細長管道和通過肝臟的消化液中。它位于肝臟的缺口處膽管在那里,隨著年齡的增長而增加,是一種緩慢發(fā)展的癌癥。 2.乳癌
乳癌在女性中很常見,年齡在這里很重要,絕經(jīng)后更常見。如果你的家族遺傳了乳腺癌,那么你患乳腺癌的風險很高,這種癌癥的治療取決于癌癥的發(fā)展階段。 1.肺癌
肺癌的發(fā)生主要是因為吸煙,吸入別人的煙也有風險。肺癌的癥狀包括胸痛、咳血、氣喘、體重減輕,治療包括化療、放療、手術(shù)、靶向藥物和免疫治療。 十大致命類型的癌癥 都是很難治愈的癌癥 GMT+8, 2025-12-19 07:08 |
最新評論
論壇熱帖
- 美到窒息!適合一個人散心旅行的
- 邂逅江南秋冬之美,浙江推出20條
- 12月份冬季出游推薦,最適合“追
- 11月最佳旅游勝地:錯過這9個地
- 周末出游攻略來了!浙江100條人
- 江西深度游攻略:解鎖千年文化與
- 12月-2月底,6個淡季旅行優(yōu)質(zhì)目
- 多地宣布免費、半價 別錯過這些
- 99%的人不敢挑戰(zhàn)!中國10大終極
- 反向旅游!這幾處寶藏小城藏著你
- 3天旅游推薦:精選小眾目的地,
- 反向旅游火出圈!5 座寶藏小城藏
- 越來越“美”的旅游!A級景區(qū)1.6
- 杭州西湖深度游攻略:解鎖千年文
- 江西旅游攻略最佳線路:5天4晚深
- 旅游消費變天了!免票、高鐵、慢
- 西安旅游攻略:四天三晚玩轉(zhuǎn)古都
- 去重慶旅游全攻略:景點、費用、
- 四川旅游攻略大全:7天玩轉(zhuǎn)成都+
- 冬日旅游好去處,冬日絕美景點,
最新資訊
- 王寶強正式起訴離婚 辟謠王寶強
- 2025旅行圈大洗牌!騰訊地圖獨家
- 途牛《2025-2026冬季旅游趨勢預
- 想“免費”逛景區(qū)?考個導游證,
- 12月休閑之旅!6個散心旅游城市
- 旅游計次票密集 “上新”!一票
- 自中國外交部發(fā)布赴日旅游風險提
- 換個角度“瞰”風景 “低空+”
- 旅游意外出險怎么辦?記住這3步
- 11月旅行狂歡:8大特色目的地,
- 2025年國內(nèi)9大必游景點全攻略|
- (走進中國鄉(xiāng)村)賞長城黃河“握
- 潮趣滿滿,浙江工業(yè)旅游創(chuàng)新場景
- 中國出入境旅游動能強勁 成全球
- 甘肅兩案例入選“2025中國旅游產(chǎn)
- 從“硬核”數(shù)據(jù)透視國慶中秋假期
- 旅游基礎(chǔ),目的地不基礎(chǔ):小眾景
- 零距離感受“大國重器” 工業(yè)+旅
- 來北京旅游,他們第一件事就是帶
- 從靜態(tài)觀賞到動態(tài)融入,山東旅游